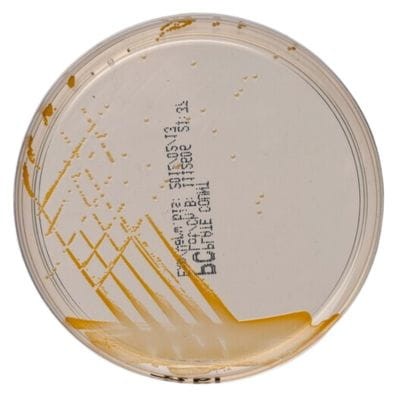
Plate Count Agar gotowa pożywka na płytkach

Podłoża gotowe na płytkach
Kategorie
Producent
Cena
-
od
do
Promocja
PCA + TTC + Neutralizing / VRBG Agar + Neutralizing - Contact Slide 1

• Opakowanie: 20 szt.
• Płytki typu dip-slide.
Plate Count Agar + OGYE Agar gotowa pożywka na płytce Dip-Slide™

• Opakowanie: 10 szt.
• Płytka: Dip-Slide™
Plate Count Agar gotowa pożywka na płytce

• Opakowanie: 10 szt.
• Płytka: 90 mm.
Plate Count Agar gotowa pożywka na płytkach
• Opakowanie: 10 szt.
• Płytka: 90 mm.
Pseudomonas C-N Selective Agar (Cetrimide Agar) gotowa pożywka do izolacji Pseudomonas aeruginosa

• Opakowanie: 10 szt.
• Płytka: 90 mm.
• Do izolacji Pseudomonas aeruginosa.
Pseudomonas CFC Selective Medium gotowa pożywka na płytkach do izolowania gatunków Pseudomonas

• Opakowanie: 10 szt.
• Płytka: 90 mm.
• Do izolacji gatunków Pseudomonas
• Wyrób medyczny: Tak
Sabouraud Dextrose Agar gotowa pożywka do oznaczania dermatofitów, grzybów i drożdży

• Opakowanie - 10 szt.
• Płytki - 90 mm
• Przeznaczenie: do oznaczania dermatofitów, grzybów i drożdży
Sabouraud Glucose + Chloramphenicol gotowe podłoże na płytkach kontaktowych

Sabouraud Glucose + Chloramphenicol gotowe podłoże na płytkach kontaktowych
• Opakowanie: 10 szt.
Sabouraud Glucose Agar gotowa pożywka na płytkach do izolacji dermatfitów

• Opakowanie: 10 szt.
• Płytka: 90 mm.
• Do izolacji dermatofitów.
• Wyrób medyczny: Tak
Sabouraud Glucose Agar with Disinhibitor gotowa pożywka na płytkach

• Opakowanie: 10 szt.
• Płytka: 90 mm.
• Do oznaczania drożdży i pleśni.
Sabouraud Glucose Chloramphenicol Selective Agar gotowa pożywka na płytkach do izolacji dermatofitów

• Opakowanie: 10 szt.
• Płytka: 90 mm
• Do izolacji dermatofitów
• Wyrób medyczny: Tak
Sabouraud Glucose Selective Agar gotowa pożywka na płytkach do izolacji dermatofitów innych grzybów i drożdży

• Opakowanie: 10 szt.
• Płytka: 90 mm.
• Do izolacji dermatyfitów, innych grzybów i drożdży.
• Wyrób medyczny: Tak
darmowa i wygodna wysyłka
już od 800 zł netto
Najwyższa jakość
produktów potwierdzona certyfikatami
Zakupy 24h na dobę
wygodne i bezpieczne
bezpłatna konsultacja
z ekspertem online


